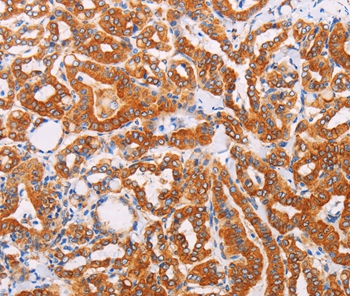

Product NameSYVN1 Antibody
Host SpeciesRabbit
ClonalityPolyclonal
PurificationAntigen affinity purification.
ApplicationsWB IHC
Species ReactivityHu Ms
SpecificityThe antibody detects endogenous levels of total SYVN1 protein.
Immunogen TypeRecombinant Protein
Immunogen DescFusion protein corresponding to residues near the C terminal of human Synovial apoptosis inhibitor 1, synoviolin
Target NameSYVN1
ConjugateUnconjugated
Other NamesDER3; HRD1
Accession NoSwiss-Prot#: Q86TM6
NCBI Gene ID: 84447
Gene Accssion: BC030530
Uniprot
Q86TM6
Gene ID
84447;
Sdspage MW68kd
Concentration0.5mg/ml
FormulationRabbit IgG in pH7.4 PBS, 0.05% NaN3, 40% Glycerol.
StorageStore at -20˚C

Yes
Yes



